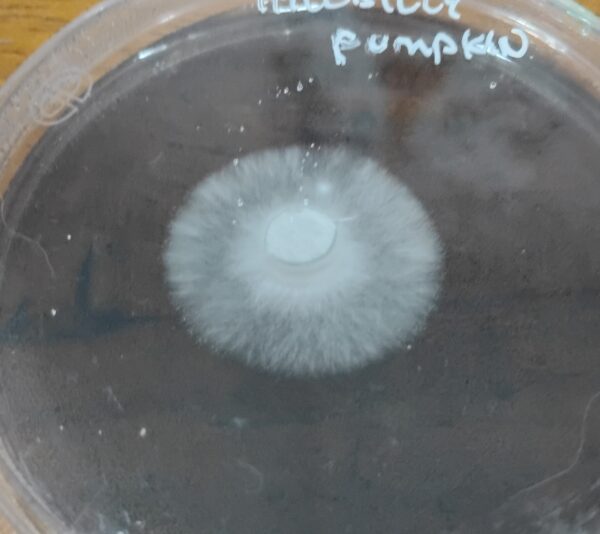
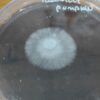
IMG_20260413_174711890_HDR

Hillbilly Pumpkin produces exceptional size fruits, sometimes resembles pumpkins. It’s a great producer for size and yeild. Extremely fun to research.
Hillbilly Pumpkin
Related products
Be the first to review “Hillbilly Pumpkin” Cancel reply
You must be logged in to post a review.

Reviews
There are no reviews yet.